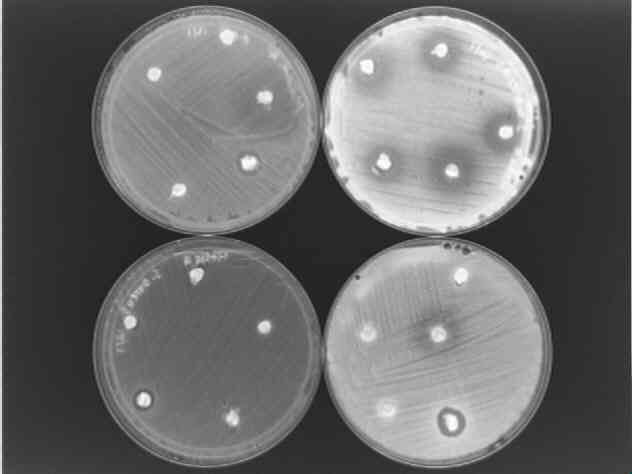
b/w antibiotic picture

click on image to enlarge.

Antibiotic Test
Click on image above to enlarge
Plates: Upper Left: E.Coli
-
Upper Right: S. Marcenes
Lower Right: B. Subtillus
Lower Left: S. Aureus
Abstract
* Introduction
* Media
* Procedure
* Results
* Discussion
Our
Theoretical Protocol * References
and Links